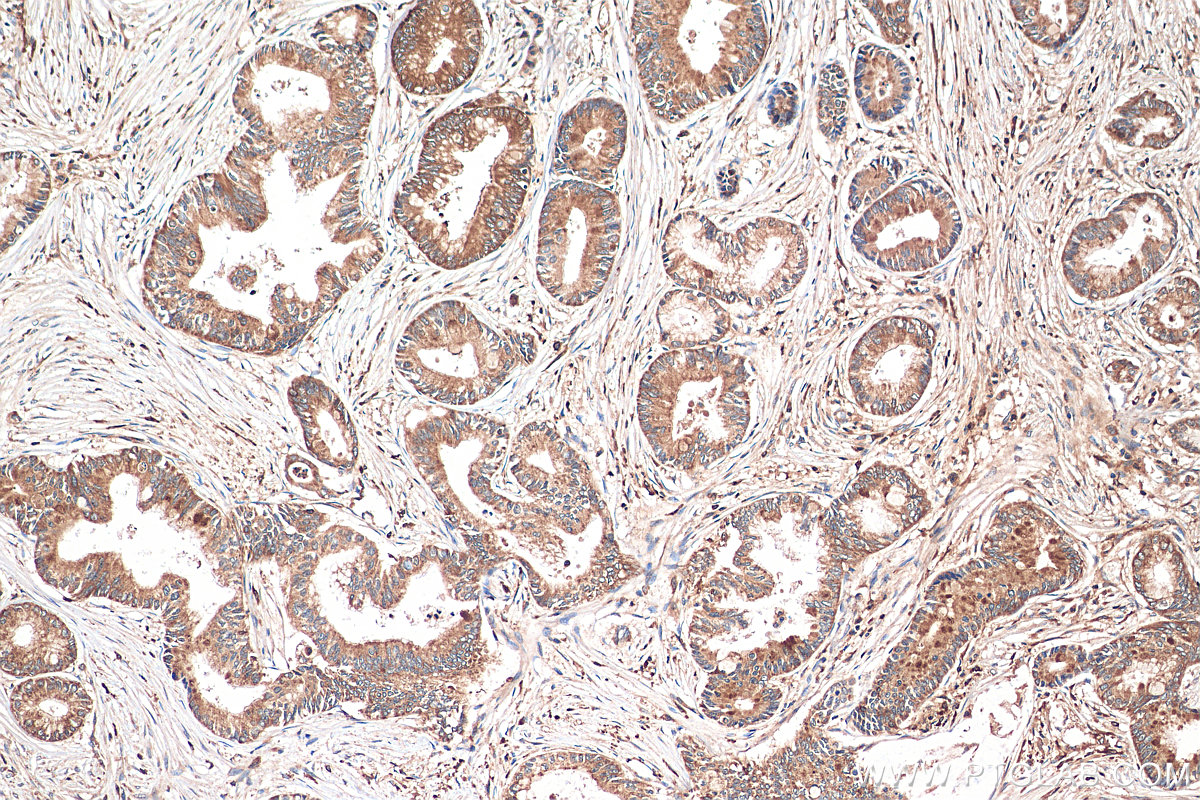
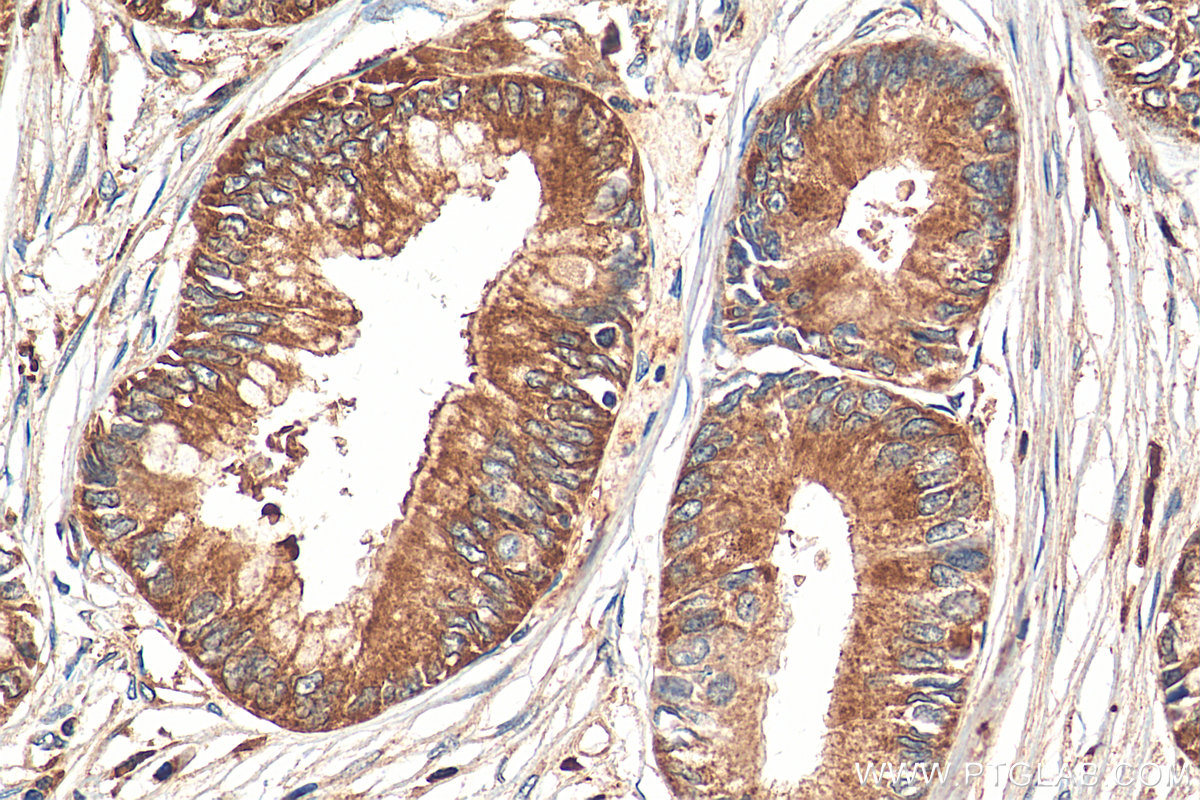

- Featured Product
- KD/KO Validated
FAM129A Polyclonal antibody
FAM129A Polyclonal Antibody for WB, IHC, IF/ICC, ELISA
Host / Isotype
Rabbit / IgG
Reactivity
human and More (1)
Applications
WB, IHC, IF/ICC, ELISA and More (1)
Conjugate
Unconjugated
验证数据展示
经过测试的应用
| Positive WB detected in | A431 cells, DU 145 cells |
| Positive IHC detected in | human pancreas cancer tissue Note: suggested antigen retrieval with TE buffer pH 9.0; (*) Alternatively, antigen retrieval may be performed with citrate buffer pH 6.0 |
| Positive IF/ICC detected in | HepG2 cells |
推荐稀释比
| Application | Dilution |
|---|---|
| Western Blot (WB) | WB : 1:500-1:3000 |
| Immunohistochemistry (IHC) | IHC : 1:50-1:500 |
| Immunofluorescence (IF)/ICC | IF/ICC : 1:50-1:500 |
| It is recommended that this reagent should be titrated in each testing system to obtain optimal results. | |
| Sample-dependent, Check data in validation data gallery. | |
产品信息
21333-1-AP targets FAM129A in WB, IHC, IF/ICC, ELISA applications and shows reactivity with human samples.
| Tested Applications | WB, IHC, IF/ICC, ELISA Application Description |
| Cited Applications | WB, IHC, IF |
| Tested Reactivity | human |
| Cited Reactivity | human, mouse |
| Immunogen | FAM129A fusion protein Ag15413 种属同源性预测 |
| Host / Isotype | Rabbit / IgG |
| Class | Polyclonal |
| Type | Antibody |
| Full Name | family with sequence similarity 129, member A |
| Synonyms | Protein FAM129A, NIBAN1, NIBAN, GIG39, Cell growth-inhibiting gene 39 protein |
| Calculated Molecular Weight | 928 aa, 103 kDa |
| Observed Molecular Weight | 150 kDa |
| GenBank Accession Number | BC030531 |
| Gene Symbol | FAM129A |
| Gene ID (NCBI) | 116496 |
| RRID | AB_10733106 |
| Conjugate | Unconjugated |
| Form | Liquid |
| Purification Method | Antigen affinity purification |
| UNIPROT ID | Q9BZQ8 |
| Storage Buffer | PBS with 0.02% sodium azide and 50% glycerol pH 7.3. |
| Storage Conditions | Store at -20°C. Stable for one year after shipment. Aliquoting is unnecessary for -20oC storage. |
实验方案
| Product Specific Protocols | |
|---|---|
| WB protocol for FAM129A antibody 21333-1-AP | Download protocol |
| IHC protocol for FAM129A antibody 21333-1-AP | Download protocol |
| IF protocol for FAM129A antibody 21333-1-AP | Download protocol |
| Standard Protocols | |
|---|---|
| Click here to view our Standard Protocols |
发表文章
| Species | Application | Title |
|---|---|---|
Front Cell Dev Biol The Regulatory Role of GBF1 on Osteoclast Activation Through EIF2a Mediated ER Stress and Novel Marker FAM129A Induction. | ||
J Cancer Niban apoptosis regulator 1 promotes gemcitabine resistance by activating the focal adhesion kinase signaling pathway in bladder cancer.
| ||
Cell Death Discov miR-4521-FAM129A axial regulation on ccRCC progression through TIMP-1/MMP2/MMP9 and MDM2/p53/Bcl2/Bax pathways. | ||
J Adv Res MiR-4521 plays a tumor repressive role in growth and metastasis of hepatocarcinoma cells by suppressing phosphorylation of FAK/AKT pathway via targeting FAM129A.
| ||
Int J Oral Sci Phenformin activates ER stress to promote autophagic cell death via NIBAN1 and DDIT4 in oral squamous cell carcinoma independent of AMPK |